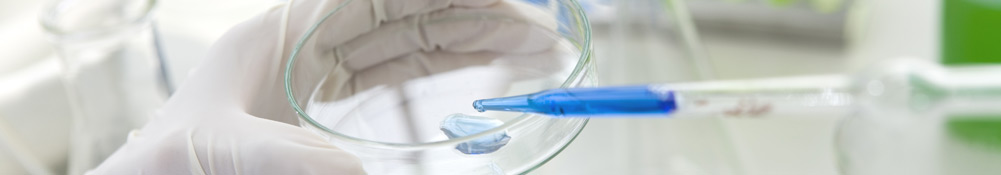
INTEREME

Soluções
Soluções
Nossas soluções foram desenvolvidas para atender necessidades específicas das empresas que atuam no segmento de saúde, considerando as particularidades inerentes ao negócio. Desta forma, procuramos suprir uma necessidade primordial das empresas nesta área: a adesão do software de gestão à sua realidade, respeitando suas diferenças e regras de negócio.
Todos os módulos possuem controle de senhas por tela e por processo, aumentando a segurança das informações contidas na base de dados da empresa. Evidenciando uma preocupação com a segurança das informações de nossos clientes, também foi implementada no sistema, uma rotina de registro de log, ou seja, qualquer acesso ou alteração na base de dados fica armazenado para consulta, sendo possível à realização de uma auditoria de dados a qualquer instante.
Gestão de Laboratórios
 |
O software de gestão de laboratórios é uma solução para gerenciamento de laboratórios de análises clínicas desenvolvida por profissionais de tecnologia, com apoio de bioquímicos especialistas, transformando-o assim, em um software extremamente adequado às rotinas e necessidades do dia-a-dia.
A preocupação com o controle de todas as rotinas e a geração de informações que darão suporte à gestão da empresa, faz com que o software de gestão de laboratórios seja uma solução extremamente eficaz, tanto no aspecto operacional quanto no gerencial.
Algumas das rotinas controladas pelo sistema são: • Controle da recepção, atendimento e recebimento de materiais; • Configuração, controle e emissão de laudos; • Emissão de laudos via e-mail ou publicação na internet; • Controle do histórico de atendimento e de resultados por paciente; • Estatísticas e relatórios de atendimentos, resultados e faturamento.
|
Módulo Faturamento
 |
O Sistema de Faturamento gerencia todos os processos para o controle das rotinas de faturamento. O sistema proporciona facilidade e agilidade para tratamento das faturas, com base em tabela de taxas e serviços. Através da parametrização e adequação das rotinas e procedimentos de faturamento, o sistema permite a redução de re-trabalho e o controle total de forma automática. Outra característica importante é o controle das contas em cada fase em que ela se encontra: digitação, fechamento, auditoria, envio e recebimento, fornecendo controle completo sobre as contas e reduzindo as perdas. Algumas das rotinas controladas pelo sistema são: • Geração e controle de faturas; • Manutenção de tabelas de preço; • Controle de vigências de preço; • Cobrança automática de taxas; • Preparado para qualquer tabela de preço (AMB, CBHPM, etc); • Integração com os principais convênios; • Estatísticas e relatórios de faturamento;
|
Módulo Laudo Web
 |
A gestão financeira é um dos principais fatores de sucesso e sobrevivência das empresas. Os controles financeiros são os instrumentos que permitem ao administrador planejar, organizar, coordenar, dirigir e controlar os recursos financeiros de sua empresa para um determinado período. O objetivo do software é auxiliar o gestor para que todas as informações relativas ao desempenho financeiro da empresa estejam à disposição. Desta forma, o controle de forma automática de todas as rotinas e procedimentos relativos aos movimentos financeiros tornam o software uma importante ferramenta no auxílio da gestão destes recursos. Algumas das rotinas controladas pelo sistema são: • Contas a Pagar/Receber; • Controle das movimentações financeiras; • Controle de Caixa; • Geração do Fluxo Caixa; • Provisões Financeiras; • Estatísticas e relatórios de financeiros;
|
